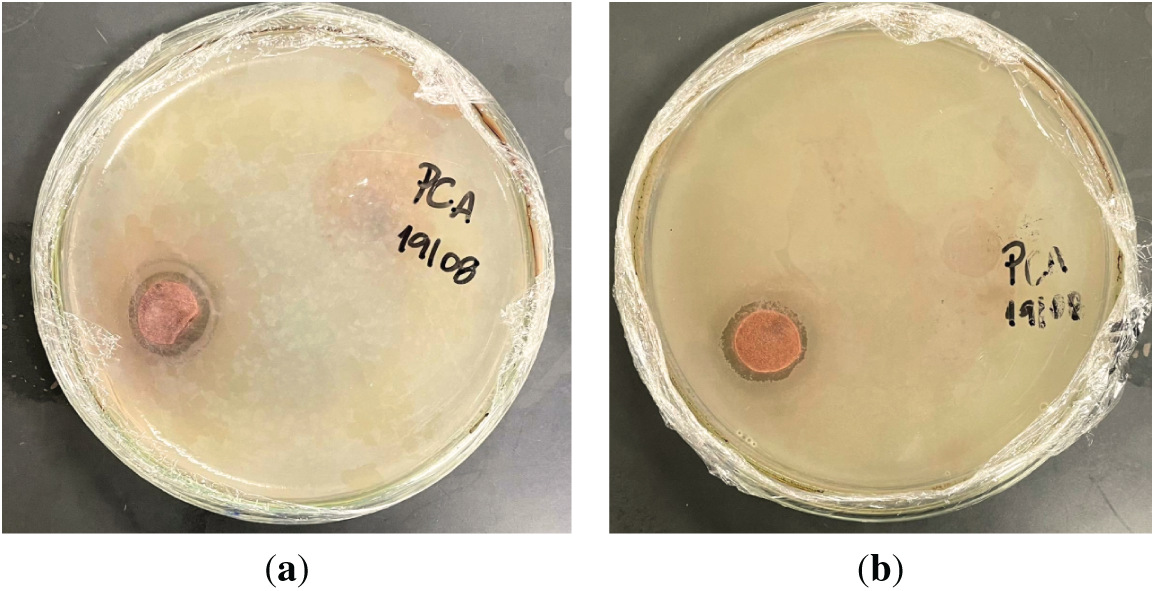
images
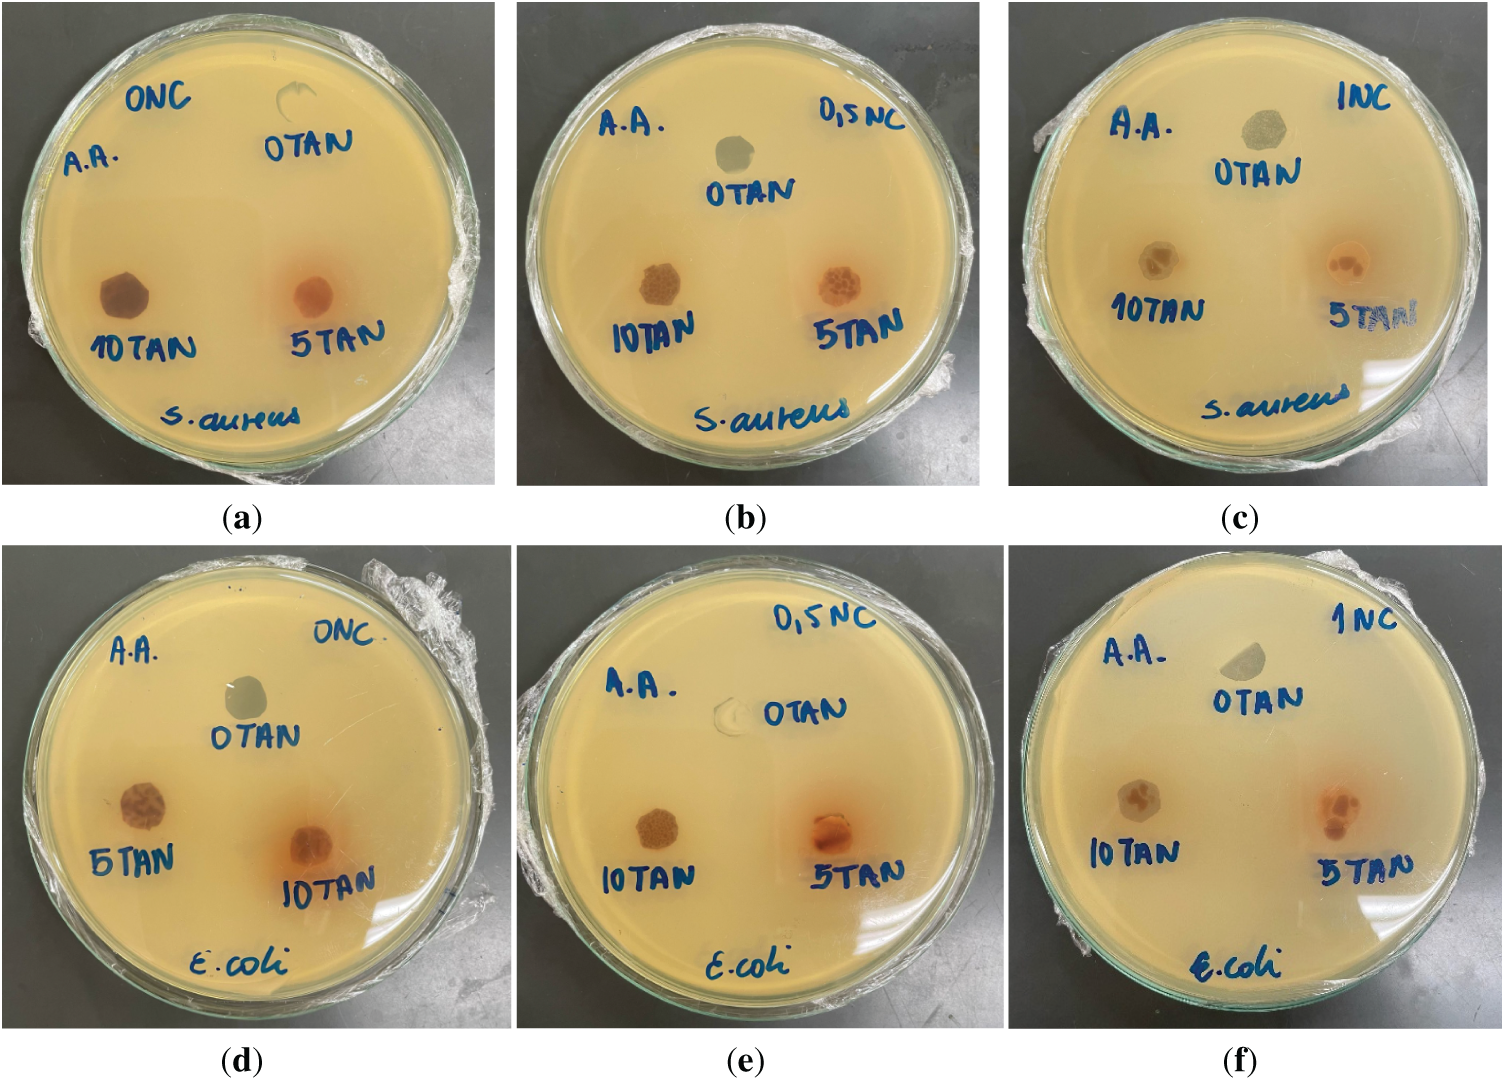
images
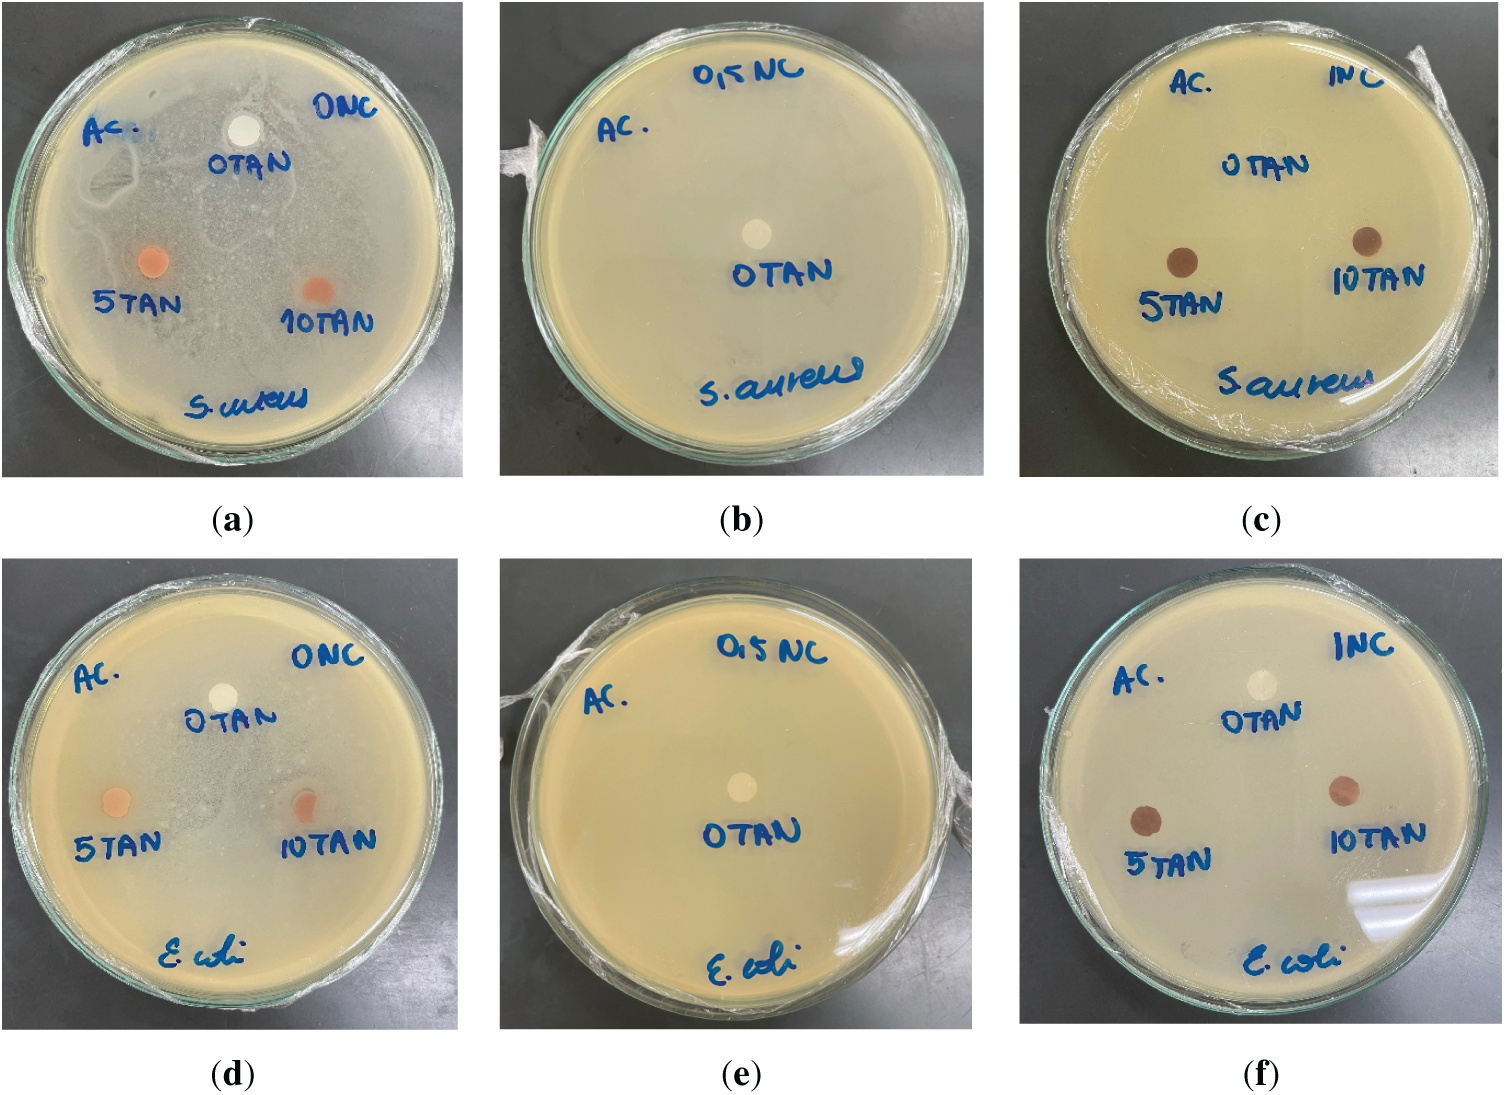
images

Open Access
ARTICLE
Effect of Tannin and Nanocellulose on Properties of Sustainable Cellulose Acetate Films
1 Graduate Program in Metallurgical Engineering (PPGEM), EEIMVR, Fluminense Federal University, Avenida dos Trabalhadores, 420, Volta Redonda, 27225-125, Rio de Janeiro, Brazil
2 Department of Agribusiness Engineering, Universidade Federal Fluminense, EEIMVR, Volta Redonda, 27255-125, Rio de Janeiro, Brazil
3 Department of Food Technology, Graduate Program in Food Science and Technology, Rural Federal University of Rio de Janeiro, Seropédica, 23897-000, Rio de Janeiro, Brazil
4 Forest Research Institute (IRF), University of Québec in Abitibi-Témiscamingue, Rouyn-Noranda, QC J9X 5E4, Canada
* Corresponding Authors: Letícia Vitorazi. Email: ; Flavia Lega Braghiroli. Email:
(This article belongs to the Special Issue: Renewable Nanostructured Porous Materials: Synthesis, Processing, and Applications)
Journal of Renewable Materials 2026, 14(2), 8 https://doi.org/10.32604/jrm.2025.02025-0163
Received 16 August 2025; Accepted 21 November 2025; Issue published 25 February 2026
Abstract
The development of sustainable materials has encouraged the use of biopolymers as alternatives to synthetic polymers. Polymeric films have stood out for their high potential in environmentally sustainable applications. Conventional cellulose acetate (CA)-based films are attractive due to their biodegradability and film-forming ability. However, their functional performance often requires enhancement through the incorporation of additives. In this context, two bio-based additives were investigated: condensed tannin (0%, 5% and 10%wt.), a natural polyphenol known for its antioxidant and antimicrobial properties, and nanocrystalline cellulose (CNC) (0%, 0.5% and 1%wt.), which act as reinforcing agents to improve mechanical strength and barrier properties. The results showed that tannin generally enhanced mechanical strength and surface uniformity while imparting contact-based antimicrobial activity. CNC reduced water uptake and improved thermal stability, but when used alone, it tended to lower mechanical performance and increase surface roughness. The combination of CNC and tannin produced performance shifts that depended strongly on their relative concentrations, with no consistent synergistic effect across all properties. In certain balanced ratios, CNC benefited from tannin’s matrix-stabilizing effect, leading to improved strength or reduced moisture absorption. Antimicrobial activity in acetic acid–based films was linked to residual acidity, whereas in acetone-based films, tannin alone was responsible for the antimicrobial effect by contact. These findings highlight that the physicochemical, mechanical, and functional performance of CA films (CAFs) is governed not only by additive type but also by the precise interplay between CNC and tannin, underscoring the need for formulation strategies tailored to the requirements of specific applications.Graphic Abstract
Keywords
The global production of plastics has surged over recent decades, increasing from approximately 2 million tons in 1950 to 368 million tons in 2019 [1]. Although synthetic polymers have enabled significant technological progress, their durability and resistance to degradation have led to serious environmental concerns. Plastics disposed of in landfills can persist for centuries, and their accumulation contributes approximately 4.5% of global greenhouse gas (GHG) emissions [2]. Incineration, often used as an alternative disposal method, releases toxic compounds such as dioxins and carbon dioxide, thereby exacerbating air pollution [3]. In response to these environmental threats, biodegradable polymers have emerged as promising alternatives. These materials break down into harmless byproducts such as water and carbon dioxide under suitable environmental and microbial conditions [4,5]. Many of them are derived from renewable sources, including starch, polylactic acid (PLA), and cellulose [6–8], thereby reducing dependency on fossil resources and encouraging sustainable development strategies [9]. Recent assessments have confirmed that bio-based and biodegradable plastic products (BPPs) can substantially reduce carbon emissions. For example, a comparative study conducted in China reported that emissions associated with 1000 conventional plastic items ranged from 52.09 to 150.36 kg CO2 eq per kilogram, while equivalent BPPs emitted only 21.06 to 56.86 kg CO2 eq, representing a reduction of 13.5% to 62.2% [10].
Among bio-based options, cellulose and its derivatives have garnered considerable attention. Cellulose acetate (CA), produced by acetylating cellulose, is one of the most widely used renewable polymers due to its excellent film-forming ability, thermal and chemical stability, and biodegradability [11,12]. CA is applied in diverse fields, including packaging, filtration, and biomedical materials [13,14]. In polymeric film fabrication, CA offers advantages such as good transparency, thermal resistance, and ease of processing [15]. However, its inherent brittleness, limited flexibility, and moderate barrier properties can restrict its broader application [16]. To address these limitations, a wide range of additives like plasticizers (e.g., glycerol), nanoparticles (e.g., cellulose nanofibrils, montmorillonite clay, aluminum hydroxide), antimicrobial agents, antioxidants (e.g., tannins), and even crosslinkers are routinely incorporated into CA films. These additives significantly enhance mechanical strength, elasticity, thermal stability, and barrier properties (water vapor, oxygen, UV), while endowing the films with functional characteristics like antimicrobial activity [17–20]. Collectively, the strategic use of additives has transformed CA-based films into high-performance materials tailored for advanced packaging, separation membranes, and biomedical applications.
Tannins, on the other hand, are abundant polyphenolic compounds extracted from plant tissues such as bark, seeds, and leaves. They are valued for their antioxidant, antimicrobial, and UV-absorbing properties [21,22]. Due to their high chemical reactivity, tannins can form hydrogen bonds and hydrophobic interactions with various polymeric matrices, making them excellent candidates for functional material design [23]. Their versatility has enabled applications in adhesives, wastewater treatment, active packaging, and biomedical devices [24–26]. Also, some reports suggest that tannins can act as crosslinking agents in biopolymer films, improving water resistance and mechanical strength. Cano [27], for example, demonstrated that the inclusion of tannin extracts enhanced the rigidity and antioxidant properties of chitosan and methylcellulose films, especially in bilayer systems.
Similarly, nanocellulose, particularly nanocrystalline cellulose (CNC), has emerged as a sustainable reinforcing agent due to its high surface area and mechanical strength. When incorporated into biopolymer matrices, nanocellulose improves film barrier properties, mechanical performance, and thermal stability [28,29]. However, the combined use of tannins and nanocellulose in CA films remains unexplored, despite their individual potential as functional biobased additives. There is a strong rationale to investigate their synergistic interaction, as tannins may contribute to crosslinking and antioxidant behavior, while nanocellulose can enhance mechanical integrity and structural reinforcement. Their co-incorporation is hypothesized to address the primary limitations of CA films such as mechanical fragility, low antioxidant activity, and limited environmental resistance, without the need for synthetic plasticizers or stabilizers. Moreover, the literature lacks systematic studies evaluating how these two bio-based additives interact within CA matrices, particularly in terms of their combined effects on film morphology, mechanical performance, and functional stability. Bridging this gap is critical for advancing the development of high-performance, biodegradable films suitable for specific applications such as active packaging and membrane technologies.
Therefore, this study aims to investigate the effects of tannin and nanocellulose incorporation into CA films. By evaluating their synergistic impact on the films’ mechanical, structural, and functional properties, the work contributes to the design of sustainable materials with improved performance and reduced ecological footprint.
For the production of CA films (CAFs) containing tannin and CNC, the following materials were used: acetic acid (99.5%, Acros Organics, Geel, Belgium) or acetone (99.5%, Sigma Aldrich, St. Louis, MO, USA) as solvents for formulations, and commercial condensed tannin was selected as an additive for these films. In all cases, deionized water and CA (Sigma Aldrich), with a weight-average molar mass of approximately 30,000 gmol−1 (determined by gel permeation chromatography, GPC), were used. CNC gel was supplied by the company Anomera (Témiscamingue, QC, Canada). According to the supplier, the CNC concentration in the gel is 7%wt., and this value was considered during solution preparation. Thus, the CNC concentrations reported in the experimental procedures refer to the dry CNC content rather than the gel itself. CNCs are supplied as an aqueous gel rather than as a dry powder. Additionally, the use of an aqueous CNC dispersion in combination with an organic solvent system may limit complete solubilization and nanoscale dispersion of the nanocrystals during solution mixing. These aspects were taken into account during formulation and are acknowledged as potential factors influencing the homogeneity of CNC distribution in the final films.
The films were prepared using the casting method, based on the procedure described by Gonçalves [30], with adaptations. For the production of the film-forming solutions, a fixed concentration of 11%wt. CA was used for all formulations. The additive concentrations were calculated relative to the weight of the polymer, corresponding to either 0.5% or 1%wt. of CNC and either 5% or 10%wt. of tannin. Control films, without tannin or CNC, were also prepared, for comparison purposes. The solid components were dissolved in a solvent mixture consisting of 80%wt. acetic acid and 20%wt. deionized water. The antimicrobial activity of CAFs prepared using acetone as the solvent was evaluated separately from those prepared with acetic acid, due to significant differences in mechanical behavior and film integrity. Regardless of the solvent used, the production method was identical.
In both solvent systems (acetone and acetic acid), tannin and CNC were incorporated in different proportions. The formulations comprised three CNC contents (0%, 0.5%, and 1%wt.) combined with three tannin contents (0%, 5%, and 10%wt.), totaling nine distinct samples. The additive combinations were designated using the format XC_YT, where XC indicates the CNC content by weight (0%, 0.5%, or 1%wt.) and YT indicates the tannin content by weight (0%, 5%, or 10%wt.). This nomenclature was applied to all formulations, regardless of the solvent used.
For the pure CAFs, without the addition of tannin or CNC, the process involved mixing acetic acid with deionized water, followed by addition of CA. Prior to polymer addition, the solvent mixture was stirred magnetically for approximately 2 min. After the polymer was added, the solution was left undisturbed to allow the polymer to swell. After approximately 20 h, once the polymer was fully swollen, the solution was stirred magnetically for about 5 h. Subsequently, the solution was left to rest for an additional 2 h to allow the release of any entrapped air bubbles. Drying of all film-forming solutions was carried out under the same conditions. 20 g of each solution was cast onto circular glass plates lined with Teflon adhesive and spread to a diameter of 15 cm, as illustrated in Fig. 1. Solvent evaporation occurred under controlled temperature conditions (60 ± 2°C) for 3 h. The resulting films were then peeled from the plates, packaged, and stored for further analysis.

Figure 1: (a) Schematic representation of CA film preparation; (b,c) digital photographs of films 0.5C_0T and 0.5C_10T, respectively
2.3 Thermal and Chemical Analyses
Fourier transform infrared spectroscopy (FTIR) was performed to evaluate the chemical structure of all the different films obtained using the Shimadzu IRTracer-100 spectrophotometer (Kyoto, Japan), over a spectral range from 4000 to 500 cm−1. To evaluate the thermal stability of the films, thermogravimetric analyses (TGA) were carried out using a STA 409 PC instrument (NETZSCH, China). The samples were placed in aluminum crucibles with an approximate mass of 12–13 mg. The thermal program consisted of a linear heating ramp from 25°C to 250°C at a rate of 10°C min−1 under a nitrogen atmosphere with a flow rate of 50 mL min−1.
Differential scanning calorimetry (DSC) analyses were performed using a DSC 1 STARe System instrument (Mettler Toledo, country). The DSC tests were conducted in accordance with ASTM E1356 [31]. The same analytical parameters were applied to all films analyzed. Samples were placed in aluminum crucibles with an approximate mass of 12 mg. The thermal program consisted of a heating cycle from 25°C to 250°C, with a constant heating rate of 10°C min−1. All analyses were carried out under a nitrogen atmosphere with a flow rate of 50 mL min−1. This procedure was developed to identify the glass transition temperature and other characteristic thermal transitions of the samples. The focus of the DSC analysis was to characterize the thermal transitions of the films in their processed state, making the first heating run sufficient for the study. This approach provided the relevant information on the effects of tannin and CNC on the CA matrix as produced.
The water absorption test was conducted in accordance with the ASTM D570 [32], which outlines the standard method for determining water absorption in plastics. Film samples were first dried in an oven at 50°C for 24 h, then cooled and immediately weighed up. The conditioned samples were then placed in a container with distilled water at 23°C, fully submerged, and left immersed for 24 h. After this period, all samples were simultaneously removed from the water, and any surface moisture was carefully dried using absorbent paper. The samples were then immediately reweighed, and the percentage of water absorption was calculated using Eq. (1):
2.5 Spectrophotometry Analysis
Spectrophotometric analysis was performed using a Konica Minolta CM 2300d spectrophotometer (Japan) to quantify the color parameters of the films before and after the water absorption tests. Measurements were conducted based on the CIE 1976 (L*, a*, b*) color space system, which allows for the evaluation of lightness (L*) and chromatic coordinates (a*: red-green axis; b*: yellow-blue axis), following the methodology described by Pérez [33]. For each film sample, five measurements were taken at different regions to ensure statistical significance.
2.6 Surface Roughness Analysis
Surface topography characterization of the films was conducted using a 3D laser confocal microscope (VK-X150, Keyence, Itasca, IL, USA). The analyses were carried out in vertical scanning mode using a 50× objective lens, covering an area of approximately 1000 × 1300 µm. The data obtained were processed with the dedicated VK-X platform software, which enabled the extraction of a range of three-dimensional roughness parameters according to ISO 25178 standards [34]. General roughness parameters included Sa (arithmetical mean height), Sq (root mean square height), and Sz (maximum height). Functional parameters derived from the Abbott–Firestone curve were also assessed, including Sk (core roughness depth), Spk (reduced peak height) and Svk (reduced valley depth). In addition, volumetric parameters were analyzed: Vmp (peak material volume), Vmc (core material volume), Vvc (core void volume), and Vvv (valley void volume). All analyses were performed in triplicate, and average values were used for comparison and interpretation of the results.
Mechanical properties were evaluated through tensile tests according to ASTM D882-125 [35], which is applicable for thin films with thicknesses below 1 mm. The tests were performed using a DL-2000 universal testing machine from EMIC, equipped with a 200 N load cell at a crosshead speed of 25 mm min−1. The influence of tannin and CNC on the mechanical properties of CAFs was assessed through tensile stress (TS), elongation at break (ε), and Young’s modulus (E).
The antimicrobial activity of the films was tested using the agar diffusion method. PCA agar (Plate Count Agar) was previously inoculated (spread plate) with 1 × 108 cells mL−1 of Staphylococcus aureus (Gram-positive) or Escherichia coli (Gram-negative), based on a 0.5 McFarland standard. To assess the antimicrobial activity, discs of each film (Ø = 9 mm) were placed on the agar in petri dishes. The plates were incubated at 35 ± 2°C for 24 h. Antimicrobial activity was confirmed by the formation of inhibition zones or reduction in microbial density. Antimicrobial assays were conducted on CAFs prepared using acetic acid and acetone as the solvent. The antimicrobial activity of the films was evaluated with all tests performed in triplicate.
To investigate the potential migration of acetic acid and tannin from the CAFs, tests were conducted in an aqueous medium using samples with and without added tannin. Film samples with equal mass were immersed in 50 mL of ultrapure water under continuous magnetic stirring at room temperature for 3 h. To monitor the possible release of acetic acid into the medium, pH measurements of the solution were taken at regular 1 min intervals throughout the immersion period using a previously calibrated Gehaka PG3000 pH meter. Additionally, to assess the migration of tannin from the films into the solution, aliquots of the water in which the films were immersed were collected every hour (0, 1, 2 and 3 h) and analyzed by UV-Vis spectrophotometry (200–1000 nm). Absorbance readings were taken using quartz cuvettes and ultrapure water as a blank.
3.1 Thermal and Chemical Analyses
To investigate the chemical interactions and structural changes resulting from the incorporation of tannin and CNC into the CA matrix, FTIR analyses were performed. For comparative purposes, the infrared spectra of all CAFs are presented in Fig. 2, along with neat CNC and tannin. The absorption bands are generally similar across all samples, with only minor variations observed in certain peaks. This can be attributed to the presence of similar chemical functionalities-such as ether and hydroxyl groups in CA, CNC, and tannin. Characteristic absorption bands of CA were identified at 1030 cm−1 and 1365 cm−1, corresponding to the C–O–C stretching and C–H stretching vibrations of the –CH3 groups in the acetate radicals, respectively. An additional band at 1735 cm−1 was attributed to the stretching vibrations of the carbonyl ester (C=O) group. Weak bands observed at 1431 cm−1 and 1365 cm−1 were associated with C–O stretching, asymmetric CH2 bending, and symmetric CH3 bending modes [36]. Bands associated with alcohol O–H stretching and bending vibrations were also noted between 2900 cm−1 and 3000 cm−1. Furthermore, CA, being an organic ester, contains the C–C(=O)–O functional group, corresponding to the absorption band at 1215 cm−1. The spectral profiles observed in Fig. 2 are qualitatively consistent with previously reported spectra in the literature [36–39].

Figure 2: FTIR spectra comparing all CAFs containing different contents of CNC (0.5% and 1%wt.) and tannin (5% and 10%wt.) as well as the control films
DSC analyses were conducted to evaluate the thermal behavior of the CAFs and the effects of additive incorporation. Fig. 3 presents the first run of the DSC thermograms of films at different concentrations of CNC and tannin. The most notable feature across all three curves is the broad endothermic event centered between approximately 50°C and 150°C, typically attributed to moisture loss and residual solvent evaporation. Additionally, towards higher temperatures (above ~200°C), endothermic deviations are observed likely linked to the melting temperature (Tm) of CA [40,41]. CNC addition intensified and broadened this endothermic signal, with the 1C_0T sample showing the deepest and widest transition. This effect can be explained by the high hydrophilicity of CNC, which favors retention of water and residual solvent during film formation. Similar broadening effects have been reported for CNC-containing polymer films, where CNC incorporation increased the moisture retention capacity and led to more pronounced endothermic transitions in this temperature region [42–44]. In CNC-free films, increasing tannin content amplified and widened the peaks, especially at 10%wt., consistent with greater water retention and structural heterogeneity. The glass transition (~50°C–150°C) became more evident with higher tannin, reflecting reduced chain mobility.

Figure 3: DSC curves comparing all CAFs containing different contents of CNC (0.5% and 1%wt.) and tannin (5% and 10%wt.) as well as the control films
CNC-tannin interactions did not show a linear or proportional trend. In films with 0.5%wt. CNC, the 0.5C_5T sample showed a stronger effect than 0.5C_10T. In films with 1%wt. CNC, 1C_0T exhibited the highest response, followed by 1C_10T, while 1C_5T showed the lowest. These variations indicate that the thermal behavior results from the combined influence of CNC, tannin, and the CA matrix, rather than the isolated effect of a single additive. A consistent event at 190°C–215°C was attributed to CA glass transition temperature (Tg), while Tm stayed within the typical 224°C–230°C range. Slightly elevated Tg values indicate restricted molecular mobility due to film composition. According to previous studies, the Tg and Tm of CA typically fall within the ranges of 198°C–205°C and 224°C–230°C, respectively [45,46]. The results obtained in this work align with these established values, particularly for Tm, which remained within the expected range. However, the Tg values observed were slightly elevated compared to those commonly reported, likely due to the specific composition of the films, which may have restricted molecular mobility within the polymer matrix.
TGA was performed to assess the thermal stability and decomposition patterns of the CAFs with varying contents of tannin and CNC. The TGA and DTG curves obtained for the nine film formulations, as well as CNC and neat tannin (Fig. 4a,b, respectively) revealed significant differences in thermal behavior depending on tannin composition. Similar to literature, neat CA film showed two stages of degradation behavior. The first stage at 100°C can be attributed to the evaporation of water whereas the second one starting from 320°C to 400°C can be attributed to the thermal degradation of acetate functional groups and glucose rings in the polymer chain. The DTG curve of the CNC gel shows two distinct peaks. The first peak can be attributed to the evaporation of physically bound and absorbed water, which commonly occurs below 150°C in cellulose-based materials [47]. The second, more intense peak around 344°C corresponds to the thermal degradation of the cellulose backbone. Similar DTG maxima in the 320°C–350°C range have been observed for CNC [48]. The incorporation of CNC alone caused no significant influence on degradation temperature (Tmax) in pure CA but increased the residual mass from 10% to nearly 14%. This trend aligns with previous studies on CA nanocomposites, which report that CNCs slightly accelerate thermal decomposition while marginally improving char yield due to their crystalline domains and restricted chain mobility [18]. Moreover, the addition of tannin significantly altered the degradation profile. Increasing the tannin content led to an earlier onset of decomposition, lowering Tmax to ~330°C–340°C, but also greatly enhanced char formation, with final residues reaching about 20%–25%.

Figure 4: (a) TGA curves comparing all CAFs containing different contents of CNC (0%, 0.5% and 1%wt.) and tannin (0%, 5% and 10%wt.) as well as the control films, neat CNC and tannin and (b) corresponding DTG curves of the same samples
This behavior is consistent with the literature, as tannin degrades at lower temperatures (200°C–300°C) but are strong char formers due to their polyphenolic aromatic structure [49]. Studies showed that tannin produces significant carbonaceous residue after pyrolysis, confirming its ability to promote char formation while reducing the onset of degradation when incorporated into polymeric matrices [50]. This trend corroborates findings from polyphenol-modified biopolymers, where these compounds initiate earlier degradation but stabilize the carbon matrix at high temperatures [51]. Although tannin incorporation reduced the onset of degradation, the marked increase in char yield (from 10% to 25%) represents a substantial gain in thermal stability at high temperatures. This behavior is industrially relevant, as the formation of stable carbonaceous residue can protect the polymer against oxidative degradation and improve its fire-retardant performance. The combination of CNC and tannin, particularly in the 1C_10T film, resulted in a 150% higher char yield compared to neat CA, evidencing a synergistic stabilization effect through the formation of an aromatic–cellulosic network. Similar improvements have been reported in polyphenol–cellulose systems, where π–π stacking and hydrogen bonding restrict chain scission and volatilization [52].
These observations are consistent with findings in other polymer systems: for instance, in polypropylene (PP)/tannin composites (crosslinked tannin), the addition of tannin increases char residue but also introduces early weight loss due to tannin decomposition around 250°C, resulting in a lower onset compared to pure PP, but improved stability at higher temperatures [53]. Similarly, in wood adhesives and furfuryl alcohol/tannin polymers, early decomposition is followed by greater residue formation at high temperature, which enhances resistance of the residual structure [54]. When both CNC and tannin were incorporated, a synergistic effect was observed. The combined systems showed the lowest Tmax values but the highest residual masses, indicating that CNC enhances the charring promoted by tannin. For example, the 1C_10T film presents the highest char yield (~25%) but the lowest Tmax (~325°C), confirming a trade-off between thermal stability and carbonization ability.
To evaluate the water absorption of the CA films (CAFs) and the influence of tannin and CNC incorporation on their water uptake behavior, gravimetric water absorption tests were conducted. As illustrated in Fig. 5, the standard deviations observed for some data points could raise concerns about the statistical relevance of the differences between average values. To address this, ANOVA analysis followed by Tukey’s post-hoc test was conducted to determine whether the variations in water uptake among the groups were statistically significant. The results revealed that all films exhibited a significant increase in water absorption percentage with the incorporation of tannin in the absence of CNC. In line with this, our findings with CA films showed that the incorporation of CNC led to a significant reduction in water absorption. This observation was supported by ANOVA p-values lower than 0.05 shown in Table A1 (see Appendix A). This behavior can be attributed to strong interactions between CNC and the CA matrix, likely promoting better dispersion and the formation of hydrogen bonds, which together reduce the material’s affinity for water, despite the inherent hydrophobicity of CNC.

Figure 5: Water absorption (%) results for all CAFs
The only exception was the difference between the 0.5C_5T and 1C_5T films. These samples did not show statistically significant differences according to Tukey’s test, meaning that increasing the CNC content in films with 5%wt. tannin did not significantly influence water absorption. This result suggests some possible hypotheses: (i) the addition of 0.5%wt. CNC may be sufficient to effectively control water absorption regardless of the tannin content, and/or (ii) the incorporation of 5%wt. tannin may represent an optimal concentration, beyond which additional tannin is not well dispersed in the matrix.
While the rise in water absorption with increasing tannin content aligns with its known hydrophilicity, linked to its high number of free hydroxyl groups [27,55] the effect of CNC on the films was unexpected. Despite the hydrophilic nature of CNC being well documented in the literature, its effect on water absorption in polymeric films depends heavily on the host matrix and the degree of interaction between the filler and polymer chains. For instance, studies with CNC incorporated into corn zein and starch-based films have shown that higher CNC loadings can increase water uptake, especially in the absence of strong interfacial compatibility or adequate crosslinking, due to the agglomeration of CNC and the formation of water-permeable pathways [56]. Similarly, some starch-based composites demonstrated a non-linear behavior, where moderate CNC content reduced water absorption, but excessive amounts reversed the trend [57]. In contrast, other studies observed a reduction in both swelling and solubility in CNC/chitosan films, attributed to the formation of hydrogen bonds that decreased the availability of free hydroxyl groups and reduced free volume in the matrix [58].
Overall, the lowest water absorption rates were recorded in samples with higher CNC content and lower tannin content. The only exception to this trend was the 1C_10T sample, which showed lower water absorption with increasing tannin content compared to other films with similar CNC content (1C_0T and 1C_5T). This behavior may be related to the interaction between CNC and tannin, which, at high additive contents, may generate localized structural heterogeneities. The results suggest that, above 5%wt. tannin, a synergy between the additives may occur, in which CNC modifies the effect of tannin, negatively influencing its ability to bind water or even reducing its tendency to leach out.
Spectrophotometric analyses were conducted to quantitatively assess the extent of the films’ color change after immersion in water. During the water absorption tests, it was observed that the water in which the films were immersed changed color, raising the hypothesis that tannin leaching had occurred. Therefore, spectrophotometric analyses were performed to assess the influence of the additives on the film colors and to quantitatively evaluate the extent of color change after immersion in water. Fig. 6a–c show the variation in the CIELAB color space parameters L* (lightness), a* (red–green axis), and b* (yellow–blue axis), respectively, for CA films containing tannin and CNC. Additionally, Table A2 (see Appendix A) shows F and p-values of ANOVA test for all parameters before immersion in water. Results showed a significant decrease in the L* component (Fig. 6a) with the gradual increase in the tannin content of the films, indicating that this addition significantly darkened them. Comparisons also showed a significant increase in the a* parameter (Fig. 6b), suggesting that tannin made the films redder. Regarding the b* parameter (Fig. 6c), the results indicate that tannin increased the yellowish hue of the films up to 5%wt., with a slight reduction at higher additions.

Figure 6: (a) L*, (b) a* and (c) b* color parameters of CAFs before and after the water absorption tester absorption test
Tukey’s post-hoc test showed that increasing tannin content from 5% to 10%wt. in films with 0.5%wt. CNC (0.5C_5T and 0.5C_10T) did not significantly reduce the yellowish hue, indicating that concentrations above 5%wt. may reach a saturation point for chromatic changes along the b* axis, likely due to poor dispersion. This aligns with observations from water absorption, suggesting that tannin’s functional effects plateau beyond this threshold.
Color variation was also not significantly influenced by the amount of CNC, either before or after immersion. After water immersion, tannin-free films showed no significant color changes, whereas all tannin-containing samples exhibited statistically significant alterations in at least two parameters, becoming less red, less yellow, and showing increased lightness—consistent with tannin leaching, as the characteristic color contributions of this additive diminished upon immersion. Notably, samples with tannin contents above 5%wt. reinforced the hypothesis of a functional saturation or synergistic behavior between additives, as the increase from 0% to 5%wt. produced a pronounced rise in b*, while the further increase to 10%wt. led to a decrease in this parameter across all formulations. Thus, the visual changes observed in this study, where CAFs shifted from transparent to increasingly brownish and opaque with the gradual addition of tannin, especially at 10%wt., are consistent with trends reported in the literature. For example, potato starch-based films, produced via casting and tannin-containing nanocellulose films and vacuum filtration, resulted in darker brown coloration [29,52]. Comparable behavior is also observed in CA–caprolactone–tannin (CA-CL-T) films prepared using caprolactone as the solvent [28]. Additionally, reduced transparency was also observed in gelatin-tannin films due to phase separation or strong interactions between tannin and the polymer matrix [59].
To investigate the impact of tannin and CNC incorporation on the surface morphology of the CAFs, surface roughness parameters were measured. Fig. 7 displays the surface roughness of the nine CAF samples containing tannin and CNC. These parameters are defined as the arithmetic mean height (Sa) that ranged from 2.25 (0.5C_0T) to 23.39 (0C_10T); maximum height (Sz) from 28.30 (0C_0T) to 198.98 (0C_10T); and root mean square height (Sq) from 2.85 (0.5C_0T) to 28.14 (0C_10T). Indeed, the surface roughness analysis revealed that the incorporation of tannin had a dominant smoothing effect on the CAFs.

Figure 7: Topographic images obtained by 3D laser confocal microscopy (100× Magnification) of (a) 0C_0T, (b) CAF, (c) 1C_0T, (d) 0C_5T, (e) 0.5C_5T, (f) 1C_5T, (g) 0C_10T, (h) 0.5C_10T and (i) 1C_10T
The maximum height (Sz) followed the same trend, reinforcing the interpretation based on Sa and Sq. CNC alone led to inconsistent effects, with 1%wt. CNC (Fig. 7c) showing lower roughness than 0.5%wt. (Fig. 7b), indicating a potential threshold for proper dispersion. Among the additional parameters, the texture aspect ratio (Str) increased with tannin content, suggesting a transition to more isotropic surfaces. 1C_10T reached the highest Str (0.80), implying a well-dispersed and uniform topography. The developed surface area ratio (Sdr) and peak curvature (Spc) also supported this observation, with low Sdr values (<0.5%) in high-tannin films and high values (>12%) in rougher ones (Fig. 7c,f), reflecting differences in surface complexity.
The other parameters (e.g., Sp, Sv, Spd, Sk, Vmp, Vvc) contributed to surface texture and load-bearing behavior, their trends generally mirrored those of Sa and Sq. Therefore, Sa and Str were sufficient to capture the dominant effects of tannin and CNC on surface morphology. The surface roughness behavior observed in this study is consistent with patterns reported in the literature involving composite biopolymer films. For instance, Zhou [60] reported that adding silica to chitosan/CA films increased surface roughness, similar to the effect observed in this study with nanocellulose. Like silica, nanocellulose acts as a rigid particulate filler that, when not well-dispersed, can create surface irregularities due to aggregation, especially at lower concentrations (e.g., 0.5C_0T). In terms of film morphology, the drying process used in this study, performed at elevated temperatures, may have contributed to surface unevenness and variability, as also reported by Kramar [61], who observed wrinkled surfaces in films cast under uncontrolled air conditions. The control sample (Fig. 7a) exhibited the highest roughness values (Sa = 17.36 µm; Sq = 22.17 µm), while the roughest surface was observed for 0.5C_0T (Fig. 7b), likely due to nanocellulose agglomeration. In contrast, films with 10%wt. tannin (Fig. 7g,i) showed the lowest roughness values (Sa = 2.25 and 3.48 µm; Sq = 2.85 and 4.45 µm), highlighting tannin’s ability to reduce topographical irregularities through hydrogen bonding and surface densification.
Although the samples’ drying was temperature-controlled, the combination of acid evaporation and localized shrinkage may have led to similar deviations, especially in the control film (0C_0T). Additionally, the smoothing effect observed with higher tannin concentrations in this study resembles results reported by De Oliveira [62]. In her work with CA films containing CeO2 nanoparticles and polyethylene glycol (PEG), roughness decreased with higher nanoparticle content, which was attributed to better dispersion and void filling. Similarly, our films with 10%wt. tannin showed a significant reduction in Sa and Sq values (0C_10T and 1C_10T), likely due to the formation of hydrogen-bonded networks that fill surface voids and promote compact film structures. This is in line with previous reports [63] that describe how functional nanostructures can enhance polymer–additive compatibility and lead to more homogeneous surfaces by reducing topographical irregularities.
The mechanical behavior of the CAFs is summarized in Table 1 and illustrated in Fig. 8. The control film (0C_0T) presented tensile stress (TS) of 48 ± 8 MPa, elongation at break (ε) of 4.0 ± 1.8%, and Young’s modulus (E) of 140 ± 2 MPa, serving as the baseline. CNC alone produced a non-linear effect on mechanical properties: at 0.5%wt. (0.5C_0T), TS and ε dropped markedly (33 ± 8 MPa; 2.9 ± 0.7%), along with a moderate modulus decrease (110 ± 6 MPa). Although CNCs are intrinsically stiff, at low concentration, they appear to have aggregated or been poorly distributed within the matrix. Under these conditions, instead of reinforcing the film, the CNCs could have acted as structural imperfections that weakened mechanical performance. Increasing CNC to 1%wt. (1C_0T) increased TS to 48 ± 2 MPa, approaching the control value, but the modulus remained low (90 ± 2 MPa). This suggests that, although the CNCs were likely better dispersed compared with 0.5%wt, they were still not well enough connected or interacting strongly enough with the CA matrix to contribute to stiffness improvements. Tannin addition produced more consistent strengthening. At 5%wt. (0C_5T), TS was maintained (45 ± 4 MPa) with ε of 3.0 ± 0.4% and E of 130 ± 2 MPa. At 10%wt. (0C_10T), TS reached its maximum across all samples (53 ± 2 MPa), with ε of 3.7 ± 0.4% and E of 120 ± 0.4 MPa. This enhancement is attributed to mobility-restricting effect of condensed tannin, which is consistent with literature on polyphenolic additives in polymer matrices. When dispersed within polymers, condensed tannins can limit chain mobility and promote the formation of dense, cohesive domains that improve stress transfer under load [14,64]. The improved tensile strength with tannin addition by ~10% relative to the control film is comparable to or exceeds gains reported for other bio-based reinforcements in CA matrices (e.g., 5%–8% for jute nanocellulose [65]). This increase, although moderate, is significant for thin CA.


Figure 8: Stress–strain curves of CAFs with different contents of CNC (0.5% and 1%wt.) and tannin (5% and 10%wt.) as well as the control films
When CNC and tannin were combined, results varied. At 0.5%wt. CNC + 5%wt. tannin (0.5C_5T), TS was 42 ± 4 MPa, ε increased to 3.7 ± 0.7%, and modulus remained stable (130 ± 2 MPa), indicating good compatibility. At 1%wt. CNC + 5%wt. tannin (1C_5T), modulus rose to 150 ± 3 MPa while TS (45 ± 3 MPa) and ε (3.7 ± 0.7%) were maintained, suggesting CNC acted as localized reinforcement in a tannin-rich matrix. However, pairing CNC with 10%wt. tannin decreased performance: 0.5C_10T and 1C_10T showed lower TS (40 ± 3 and 39 ± 12 MPa), reduced modulus (~100 MPa), and no gain in ductility, likely due to phase incompatibility, hydrogen-bond saturation, or nanofiller agglomeration. Overall, tannin was the main contributor to strength improvement, whereas CNC’s reinforcing effect depended on achieving good dispersion and matrix compatibility.
Importantly, while 0C_10T achieved the best combination of strength and moderate ductility, 1C_5T presented the highest modulus, suggesting potential for applications requiring increased stiffness. Nonetheless, the lack of a consistent synergistic effect between CNC and tannin indicates possible competition for interaction sites within the matrix, leading to localized heterogeneity or filler aggregation [66]. These findings are consistent with observations from other formulations, such as CA crosslinked with caprolactone and tannin (CA–CL–T), which achieved balanced mechanical properties only through chemical coupling strategies [28]. Therefore, while tannin alone proved effective as a reinforcing agent, further refinement in CNC dispersion, surface functionalization, or use of compatibilizers may be necessary to fully exploit the potential of combined CNC–tannin systems in CA matrices. A summary of the ANOVA and Tukey test for the TS of the CAF samples is presented in Table A4 (see Appendix A). The Tukey post hoc analysis indicates that the TS of sample 0C_10T differs significantly from the samples 1C_10T, 0.5C_0T, 1C_5T, and 0C_5T, as evidenced by p-values below 0.05. No statistically significant differences were observed among the remaining sample pairs, suggesting that the effect of the additives on TS is pronounced only in specific compositions.
To assess the potential of the CAFs for antimicrobial applications, their inhibitory activity was tested against two representative bacterial strains: Staphylococcus aureus (Gram-positive) and Escherichia coli (Gram-negative). For the evaluation of the activity of neat tannin against these bacterial strains, the method employed consisted of impregnating a filter paper with a 4%wt. tannin solution in water prior to placement on the bacterial culture. Fig. 9 presents the results of pure tannin against S. aureus (Fig. 9a) and E. coli (Fig. 9b). As can be observed, for both bacterial strains, the commercial pure tannin exhibited clear antimicrobial activity, characterized by the formation of an inhibition halo around the sample placed on the agar.
Figure 9: Antimicrobial activity of neat tannin against (a) Staphylococcus aureus and (b) Escherichia coli, showing the formation of inhibition halos around the samples
The results (Fig. 10) showed that all films prepared with acetic acid exhibited contact-based antimicrobial activity, evidenced by the absence of bacterial growth on their surfaces. However, none of the samples produced inhibition zones, which are characterized by clear halos around the sample where no bacterial growth occurs, indicating diffusion of antimicrobial compounds into the culture medium. This outcome suggests that the antimicrobial effect observed is limited to direct contact between the film and the microorganisms.
Figure 10: Antimicrobial activity of CAFs with 0%wt. (a,d), 0.5%wt. (b,e), and 1%wt. (c,f) CNC, varying the amount of added tannin (0%, 5% and 10%wt.), against Staphylococcus aureus and Escherichia coli using acetic acid as solvent
Interestingly, even the films without tannin and CNC inhibited bacterial growth on their surfaces, implying that the antimicrobial effect may be attributed, at least in part, to the presence of residual acetic acid from the solvent. This hypothesis is supported by the results presented in Fig. 11, in which films containing both tannin and nanocellulose but prepared using acetone as the solvent did not prevent bacterial growth on their surfaces. In that set of experiments, pure CAFs produced with acetone exhibited no antimicrobial activity, while the addition of tannin showed inhibition of bacterial growth by contact. These findings indicate that both tannin and residual acetic acid contribute independently to the antimicrobial properties of the films. However, no additive or cumulative effect was observed when both were present, without synergistic enhancement when combined. Additionally, the visual observation of color diffusion into the agar, resembling that of tannin, indicates its migration into the medium; however, the absence of an inhibition halo suggests that its antimicrobial activity may have been suppressed by the presence of acetic acid, possibly due to interactions that compromised its bioactive properties.
Figure 11: Antimicrobial activity of CAFs with 0%wt. (a,d), 0.5%wt. (b,e), and 1%wt. (c,f) CNC, varying the amount of added tannin (0%, 5% and 10%wt.), against Staphylococcus aureus and Escherichia coli using acetone as the solvent
The results obtained in this study are consistent with findings reported in the literature showing the relevance of tannin and nanocellulose as bioactive agents in sustainable polymeric matrices for antimicrobial applications. Halim [67] and Cano [27] also observed that the incorporation of tannins into polymer matrices like chitosan and methylcellulose not only promoted structural interactions (e.g., hydrogen bonding and hydrophobic interactions) but also contributed to functional properties, including antimicrobial activity. Similarly, Missio [29] reported the successful development of hybrid films combining tannins and cellulose nanofibrils with antioxidant properties, highlighting the synergistic potential between these additives. Moreover, Fleck [68] exploring the use of phenolic-rich jaboticaba peel extract, has also proven effective in inhibiting both Gram-positive and Gram-negative bacteria.
Following the antimicrobial assays, visual inspection of the agar revealed color changes around the films, suggesting that tannin may have migrated from the films into the surrounding medium. To assess the extent of component migration, additional analyses were performed. pH measurements of the aqueous medium were used to detect potential solvent or additive leaching, while UV-Vis spectroscopy was employed to specifically quantify the release of tannin. For both samples, a significant drop in water absorption tester pH was observed within the first 30 min of immersion, followed by a gradual stabilization of the measured values (Fig. 12a). This behavior indicates an initial rapid release of acidic substances into the aqueous medium, followed by a slower diffusion regime, suggesting that most of the migration occurs shortly after immersion. Since the only common components between the two film formulations are the base polymer (CA) and the acetic acid solvent, and given that the pH decrease occurred regardless of the presence of tannin, it can be inferred that residual acetic acid in the films diffused into the water absorption tester. This result supports the hypothesis that the antimicrobial activity observed in the films, even in the absence of tannin, may be attributed to the presence of residual acetic acid, which provides sufficient acidity to inhibit microbial growth by contact.

Figure 12: Migration behavior of components from CAFs into ultrapure water absorption tester. (a) Variation in pH over time during immersion of 0C_0T and 0C_10T; (b) UV–Vis absorbance spectra of immersion water absorption tester after 3 h to assess tannin release; (c) Visual evidence of component migration in CAFs before and after water absorption tester immersion
Additionally, UV-Vis spectrophotometric analysis was carried out to investigate the potential migration of tannin from the films into the water absorption tester (Fig. 12b). Regarding the acetone formulations, this solvent evaporates completely during film formation, leaving no residual species that could act as antimicrobial agents. Additionally, Fig. 12c illustrates the effect of component migration on the coloration of the films. Images of 0C_0T and 0C_10T were taken both before and after immersion in water absorption tester, clearly showing the visible color changes associated with the leaching of tannin from the film matrix.
The spectra obtained for the 0C_0T showed absorbance levels nearly identical to ultrapure water absorption tester throughout the experiment, indicating no release of UV-visible absorbing compounds. In contrast, the spectra from the solution in which 0C_10T was immersed showed a progressive increase in absorbance over time. This suggests the diffusion of tannin due to the presence of hydroxyl groups in its structure, being highly soluble in water. Furthermore, the film formulation did not include any chemical anchoring agents (i.e., crosslinkers), meaning the tannin was not chemically bound to the CA matrix but merely physically dispersed. The absence of covalent bonding or complexation between tannin and the polymer facilitates its leaching into the aqueous medium. In contrast, literature reports have demonstrated that the use of specific linking agents, such as caprolactone activated by diphenyl phosphate (DPP), enables the formation of stable networks incorporating CA and tannins [60,69–72]. These networks, formed via reactive mechanisms like ring-opening and grafting, improve the compatibility and stability of the components, significantly reducing the risk of additive leaching.
Indeed, this migration behavior is particularly undesirable in applications where prolonged retention or controlled release of active compounds is necessary, such as in food packaging with antioxidant or antimicrobial properties or in biomedical slow-release systems. The rapid loss of tannin compromises both the functional efficacy and the chemical stability of the films, and may also lead to contamination of the surrounding environment [73]. Moreover, the differing migration behavior of the film components highlights the importance of evaluating the chemical stability of natural additives in polymeric formulations.
Table 2 compares mechanical properties of different bioresorced films. When compared to literature-reported CA systems, the 0C_10T film developed in this study exhibits a balanced mechanical profile that is competitive with or superior to several reported formulations. Its tensile strength (53 ± 2 MPa) is comparable to or higher than CA films reinforced with jute-derived nanocrystals (55.4 MPa) or CNF-based systems (47.6 MPa), while being achieved without plasticizers or additional crosslinkers. Unlike electrospun or solvent-specific formulations that often present very low elongation at break (e.g., 0.57% and 0.73%), 0C_10T maintains moderate ductility (3.7 ± 0.4%), which is advantageous for applications that require more flexibility. Although its elastic modulus (0.12 GPa) is lower than some highly rigid nanofiber-reinforced membranes, those systems typically sacrifice ductility and processability. Compared to CA films modified with glycerol or produced via copolymer routes, where tensile strength drops significantly, the use of condensed tannin provided notable reinforcement without compromising structural integrity. Together, these attributes position the 0C_10T film as a promising and more sustainable alternative that achieves mechanical performance through a bio-based additive, under accessible processing conditions, and without relying on synthetic plasticizers or complex fabrication methods.
Incorporating CNC and condensed tannin into CAFs produced diverse property changes, driven by additive type, concentration, and dispersion. No universal synergy was observed, but certain combinations yielded benefits for specific targets, focusing on tailoring the formulation to the intended applications. Mechanically, tannin, especially at 10%wt., reinforced the films, improving tensile strength and maintaining moderate elongation and modulus. CNC alone often reduced strength and ductility, but low CNC levels (e.g., 0.5%wt.) with tannin may improve performance, suggesting tannin can offset CNC’s brittleness at optimal concentration. In relation to water uptake, CNC generally reduced absorption via denser packing, while tannin increased it due to its hydrophilicity. Thermally, CNC does not significantly affect the degradation temperature but increases char yield, tannin lowers Tmax while strongly promoting carbonization, producing a synergistic effect that maximizes residual mass. Morphologically, CNC increased roughness and heterogeneity, while tannin smoothed surfaces and darkened films. Antimicrobial tests showed acetic acid–based films had contact activity due to residual acidity, independent of tannin or CNC whereas tannin enhanced activity in acetone-based films. Additive migration tests confirmed tannin leaches into aqueous media, potentially reducing long-term performance and raising contamination concerns, indicating a need for retention strategies such as crosslinking. Overall, CNC–tannin–CAFs offer a versatile platform whose properties can be tuned through additive ratio, dispersion, and solvent choice to match diverse application demands. Overall, the individual contributions of tannin and CNC, though moderate when analyzed separately, translate into meaningful multifunctional improvements when contextualized within biodegradable CA-based systems. Tannin acted primarily as a reinforcing agent and thermal stabilizer, improving tensile strength and char yield without the need for synthetic plasticizers. CNC contributed to water resistance and char generation at high temperatures. These effects, while not dramatically altering single metrics, collectively enhance durability, reduce moisture sensitivity, and increase long-term performance of CA films, thereby providing tangible benefits for sustainable packaging and bioactive coatings. Looking ahead, the use of systematic optimization strategies, such as Design of Experiments (DoE), could allow a deeper investigation of the interactive effects between tannin and CNC. Approaches like factorial or Box–Behnken designs were beyond the scope of this work due to the substantial number of formulations and replicates required, but they represent valuable tools for subsequent research aiming to better map additive interactions and optimize film performance. Additionally, strategies to prevent tannin leaching should be explored in future studies, such as those involving caprolactone in combination with catalysts like diphenyl phosphate,which have demonstrated potential to create crosslinked tannin–CNC–CA networks with enhanced mechanical properties, moisture resistance, and UV stability. Overall, CNC–tannin–CAFs remain a promising platform whose properties can be tuned through additive ratio, dispersion, solvent selection, and, in future, advanced design and crosslinking strategies to meet diverse application demands.
Acknowledgement: The authors acknowledge the Escola de Engenharia Industrial Metalúrgica de Volta Redonda (EEIMVR—UFF) for the use of the Applied Mechanics Laboratory of the Mechanical Engineering Department, as well as the Multiuser Laboratory for Microstructural Characterization (LMCMicro) for access to TGA and DSC equipment. Leticia Vitorazi gratefully acknowledges the financial support from the Fundação Carlos Chagas Filho de Amparo à Pesquisa do Estado do Rio de Janeiro (FAPERJ) through the Young Scientist of Our State Fellowship (Bolsa Jovem Cientista do Nosso Estado), process number E-26/200.129/2023.
Funding Statement: This research was funded by the Coordenação de Aperfeiçoamento de Pessoal de Nível Superior (CAPES, https://www.gov.br/capes) and by Mitacs (https://www.mitacs.ca), under grant number IT42277. Letícia Vitorazi acknowledges support from FAPERJ (https://www.faperj.br) under grant number E-26/200.129/2023—Bolsa JCNE/FAPERJ. Flavia Braghiroli acknowledges the Natural Sciences and Engineering Research Council of Canada (NSERC), Alliance project ALLRP 585984-23 and the Fonds de recherche du Québec—Nature et technologies (FRQNT) (10.69777/355295), grant number 202250.
Author Contributions: The authors confirm contribution to the paper as follows: Conceptualization, José Marcelo Faria de Queiroz Júnior, Flavia Lega Braghiroli and Letícia Vitorazi; Methodology, José Marcelo Faria de Queiroz Júnior, Nathália Ramos de Melo, Ulisses Oliveira Costa, Flavia Lega Braghiroli and Letícia Vitorazi; Software, José Marcelo Faria de Queiroz Júnior, Ulisses Oliveira Costa, Flavia Lega Braghiroli and Letícia Vitorazi; Validation, José Marcelo Faria de Queiroz Júnior, Nathália Ramos de Melo, Ulisses Oliveira Costa, Flavia Lega Braghiroli and Letícia Vitorazi; Formal analysis, José Marcelo Faria de Queiroz Júnior, Flavia Lega Braghiroli and Letícia Vitorazi; Investigation, José Marcelo Faria de Queiroz Júnior, Nathália Ramos de Melo, Ulisses Oliveira Costa, Flavia Lega Braghiroli and Letícia Vitorazi; Resources, Nathália Ramos de Melo, Flavia Lega Braghiroli and Letícia Vitorazi; Data curation, José Marcelo Faria de Queiroz Júnior, Ulisses Oliveira Costa and Letícia Vitorazi; Writing—original draft preparation, José Marcelo Faria de Queiroz Júnior; Writing—review and editing, José Marcelo Faria de Queiroz Júnior, Nathália Ramos de Melo, Ulisses Oliveira Costa, Flavia Lega Braghiroli and Letícia Vitorazi; Supervision, Flavia Lega Braghiroli and Letícia Vitorazi; Project administration, José Marcelo Faria de Queiroz Júnior, Flavia Lega Braghiroli and Letícia Vitorazi; Funding acquisition, Flavia Lega Braghiroli and Letícia Vitorazi. All authors reviewed the results and approved the final version of the manuscript.
Availability of Data and Materials: The data that support the findings of this study are available from the Corresponding Author, Flavia Lega Braghiroli, upon reasonable request.
Ethics Approval: Not applicable.
Conflicts of Interest: The authors declare no conflicts of interest to report regarding the present study.




References
1. Pilapitiya PGCN, Ratnayake AS. The world of plastic waste: a review. Clean Mater. 2024;11:100220. doi:10.1016/j.clema.2024.100220. [Google Scholar] [CrossRef]
2. Cabernard L, Pfister S, Oberschelp C, Hellweg S. Growing environmental footprint of plastics driven by coal combustion. Nat Sustain. 2021;5(2):139–48. doi:10.1038/s41893-021-00807-2. [Google Scholar] [CrossRef]
3. Piscopo A, Zappia A, De Bruno A, Pozzo S, Limbo S, Piergiovanni L, et al. Use of biodegradable materials as alternative packaging of typical Calabrian Provola cheese. Food Packag Shelf Life. 2019;21(1):100351. doi:10.1016/j.fpsl.2019.100351. [Google Scholar] [CrossRef]
4. Mukherjee C, Varghese D, Krishna JS, Boominathan T, Rakeshkumar R, Dineshkumar S, et al. Recent advances in biodegradable polymers—properties, applications and future prospects. Eur Polym J. 2023;192(9):112068. doi:10.1016/j.eurpolymj.2023.112068. [Google Scholar] [CrossRef]
5. Richardson JJ, Liang K, Kempe K, Ejima H, Cui J, Caruso F. Immersive polymer assembly on immobilized particles for automated capsule preparation. Adv Mater. 2013;25(47):6874–8. doi:10.1002/adma.201302696. [Google Scholar] [PubMed] [CrossRef]
6. Gamage A, Thiviya P, Mani S, Ponnusamy PG, Manamperi A, Evon P, et al. Environmental properties and applications of biodegradable starch-based nanocomposites. Polymers. 2022;14(21):4578. doi:10.3390/polym14214578. [Google Scholar] [PubMed] [CrossRef]
7. Jiang Z, Ho S-H, Wang X, Li Y, Wang C. Application of biodegradable cellulose-based biomass materials in wastewater treatment. Environ Pollut. 2021;290:118087. doi:10.1016/j.envpol.2021.118087. [Google Scholar] [PubMed] [CrossRef]
8. Taib N-AAB, Rahman MR, Huda D, Kuok KK, Hamdan S, Bakri MKB, et al. A review on poly lactic acid (PLA) as a biodegradable polymer. Polym Bull. 2023;80(2):1179–213. doi:10.1007/s00289-022-04160-y. [Google Scholar] [CrossRef]
9. Bhatia S. Natural polymers vs synthetic polymer. In: Natural polymer drug delivery systems. Cham, Switzerland: Springer International Publishing; 2016. p. 95–118. doi:10.1007/978-3-319-41129-3_3. [Google Scholar] [CrossRef]
10. Chen G, Li J, Sun Y, Wang Z, Leeke GA, Moretti C, et al. Replacing traditional plastics with biodegradable plastics: impact on carbon emissions. Engineering. 2024;32(7):152–62. doi:10.1016/j.eng.2023.10.002. [Google Scholar] [CrossRef]
11. Candido RG, Gonçalves AR. Synthesis of cellulose acetate and carboxymethylcellulose from sugarcane straw. Carbohydr Polym. 2016;152:679–86. doi:10.1016/j.carbpol.2016.07.071. [Google Scholar] [PubMed] [CrossRef]
12. Su X, Chen Z, Zhang Y. Preparation and characterization of waterborne cellulose emulsion based on nitrocellulose modified with acrylic copolymer. Chem Pap. 2017;71(10):2145–52. doi:10.1007/s11696-017-0207-7. [Google Scholar] [CrossRef]
13. Liu H, Hsieh Y. Ultrafine fibrous cellulose membranes from electrospinning of cellulose acetate. J Polym Sci B Polym Phys. 2002;40(19):2119–29. doi:10.1002/polb.10261. [Google Scholar] [CrossRef]
14. Yang W, Sousa AMM, Fan X, Jin T, Li X, Tomasula PM, et al. Electrospun ultra-fine cellulose acetate fibrous mats containing tannic acid–Fe3+ complexes. Carbohydr Polym. 2017;157(10):1173–9. doi:10.1016/j.carbpol.2016.10.078. [Google Scholar] [PubMed] [CrossRef]
15. Vatanpour V, Pasaoglu ME, Barzegar H, Teber OO, Kaya R, Bastug M, et al. Cellulose acetate in fabrication of polymeric membranes: a review. Chemosphere. 2022;295(1):133914. doi:10.1016/j.chemosphere.2022.133914. [Google Scholar] [PubMed] [CrossRef]
16. Carolin CF, Kamalesh T, Kumar PS, Hemavathy RV, Rangasamy G. A critical review on sustainable cellulose materials and its multifaceted applications. Ind Crops Prod. 2023;203(25):117221. doi:10.1016/j.indcrop.2023.117221. [Google Scholar] [CrossRef]
17. Rehman A, Jahan Z, Sher F, Noor T, Khan Niazi MB, Akram MA, et al. Cellulose acetate-based sustainable nanostructured membranes for environmental remediation. Chemosphere. 2022;307(5):135736. doi:10.1016/j.chemosphere.2022.135736. [Google Scholar] [PubMed] [CrossRef]
18. Cindradewi AW, Bandi R, Park C-W, Park J-S, Lee E-A, Kim J-K, et al. Preparation and characterization of cellulose acetate film reinforced with cellulose nanofibril. Polymers. 2021;13(17):2990. doi:10.3390/polym13172990. [Google Scholar] [PubMed] [CrossRef]
19. Teixeira SC, Silva RRA, De Oliveira TV, Stringheta PC, Pinto MRMR, Soares NDF. Glycerol and triethyl citrate plasticizer effects on molecular, thermal, mechanical, and barrier properties of cellulose acetate films. Food Biosci. 2021;42(4):101202. doi:10.1016/j.fbio.2021.101202. [Google Scholar] [CrossRef]
20. Jiang Z, Ngai T. Recent advances in chemically modified cellulose and its derivatives for food packaging applications: a review. Polymers. 2022;14(8):1533. doi:10.3390/polym14081533. [Google Scholar] [PubMed] [CrossRef]
21. Arbenz A, Avérous L. Chemical modification of tannins to elaborate aromatic biobased macromolecular architectures. Green Chem. 2015;17(5):2626–46. doi:10.1039/C5GC00282F. [Google Scholar] [CrossRef]
22. Das AK, Islam MN, Faruk MO, Ashaduzzaman M, Dungani R. Review on tannins: extraction processes, applications and possibilities. S Afr J Bot. 2020;135(6):58–70. doi:10.1016/j.sajb.2020.08.008. [Google Scholar] [CrossRef]
23. Koopmann A-K, Schuster C, Torres-Rodríguez J, Kain S, Pertl-Obermeyer H, Petutschnigg A, et al. Tannin-based hybrid materials and their applications: a review. Molecules. 2020;25(21):4910. doi:10.3390/molecules25214910. [Google Scholar] [PubMed] [CrossRef]
24. Chen L, Wang Y, Zia-ud-Din, Fei P, Jin W, Xiong H, et al. Enhancing the performance of starch-based wood adhesive by silane coupling agent (KH570). Int J Biol Macromol. 2017;104(3):137–44. doi:10.1016/j.ijbiomac.2017.05.182. [Google Scholar] [PubMed] [CrossRef]
25. Vera M, Mella C, García Y, Jiménez VA, Urbano BF. Recent advances in tannin-containing food biopackaging. Trends Food Sci Technol. 2023;133(1–2):28–36. doi:10.1016/j.tifs.2023.01.014. [Google Scholar] [CrossRef]
26. Baldwin A, Booth BW. Biomedical applications of tannic acid. J Biomater Appl. 2022;36(9):1503–23. doi:10.1177/08853282211058099. [Google Scholar] [PubMed] [CrossRef]
27. Cano A, Contreras C, Chiralt A, González-Martínez C. Using tannins as active compounds to develop antioxidant and antimicrobial chitosan and cellulose-based films. Carbohydr Polym Technol Appl. 2021;2(4):100156. doi:10.1016/j.carpta.2021.100156. [Google Scholar] [CrossRef]
28. Zhou Y, Zheng L, Chen X, Huang Y, Essawy H, Du G, et al. Developing high performance biodegradable film based on crosslinking of cellulose acetate and tannin using caprolactone. Int J Biol Macromol. 2024;262(2):130067. doi:10.1016/j.ijbiomac.2024.130067. [Google Scholar] [PubMed] [CrossRef]
29. Missio AL, Mattos BD, Ferreira DDF, Magalhães WLE, Bertuol DA, Gatto DA, et al. Nanocellulose–tannin films: from trees to sustainable active packaging. J Clean Prod. 2018;184:143–51. doi:10.1016/j.jclepro.2018.02.205. [Google Scholar] [CrossRef]
30. Gonçalves SM, Dos Santos DC, Motta JFG, Dos Santos RRD, Chávez DWH, Melo NRD. Structure and functional properties of cellulose acetate films incorporated with glycerol. Carbohydr Polym. 2019;209(6):190–7. doi:10.1016/j.carbpol.2019.01.031. [Google Scholar] [PubMed] [CrossRef]
31. E37 Committee. Test method for assignment of the glass transition temperatures by differential scanning calorimetry. Philadelphia, PA, USA: ASTM International; 2023. doi:10.1520/E1356-08R14. [Google Scholar] [CrossRef]
32. ASTM International. Standard test method for water absorption of plastics. Philadelphia, PA, USA: ASTM International; 2022 [cited 2025 Jun 13]. Available from: https://store.astm.org/d0570-22.html. [Google Scholar]
33. Pérez MDM, Ghinea R, Rivas MJ, Yebra A, Ionescu AM, Paravina RD, et al. Development of a customized whiteness index for dentistry based on CIELAB color space. Dent Mater. 2016;32(3):461–7. doi:10.1016/j.dental.2015.12.008. [Google Scholar] [PubMed] [CrossRef]
34. Fredrich JT. 3D imaging of porous media using laser scanning confocal microscopy with application to microscale transport processes. Phys Chem Earth Part A. 1999;24(7):551–61. doi:10.1016/S1464-1895(99)00079-4. [Google Scholar] [CrossRef]
35. ASTM International. Standard test method for tensile properties of thin plastic sheeting. Philadelphia, PA, USA: ASTM International; 2018. doi:10.1520/D0882-18. [Google Scholar] [CrossRef]
36. Celuppi LCM, Capelezzo AP, Cima LB, Zeferino RCF, Carniel TA, Zanetti M, et al. Microbiological, thermal and mechanical performance of cellulose acetate films with geranyl acetate. Int J Biol Macromol. 2023;228:517–27. doi:10.1016/j.ijbiomac.2022.12.170. [Google Scholar] [PubMed] [CrossRef]
37. Toprak C, Agar JN, Falk M. State of water in cellulose acetate membranes. J Chem Soc Faraday Trans 1. 1979;75:803–13. doi:10.1039/f19797500803. [Google Scholar] [CrossRef]
38. Oldani M, Schock G. Characterization of ultrafiltration membranes by infrared spectroscopy, ESCA, and contact angle measurements. J Membr Sci. 1989;43(2):243–58. doi:10.1016/S0376-7388(00)85101-7. [Google Scholar] [CrossRef]
39. Murphy D, De Pinho MN. An ATR-FTIR study of water in cellulose acetate membranes prepared by phase inversion. J Membr Sci. 1995;106(3):245–57. doi:10.1016/0376-7388(95)00089-U. [Google Scholar] [CrossRef]
40. Cardea S, De Marco I. Cellulose acetate and supercritical carbon dioxide: membranes, nanoparticles, microparticles and nanostructured filaments. Polymers. 2020;12(1):162. doi:10.3390/polym12010162. [Google Scholar] [PubMed] [CrossRef]
41. Erdmann R, Kabasci S, Heim H-P. Thermal properties of plasticized cellulose acetate and its β-relaxation phenomenon. Polymers. 2021;13(9):1356. doi:10.3390/polym13091356. [Google Scholar] [PubMed] [CrossRef]
42. Guo X, Wu Y, Xie X. Water vapor sorption properties of cellulose nanocrystals and nanofibers using dynamic vapor sorption apparatus. Sci Rep. 2017;7(1):14207. doi:10.1038/s41598-017-14664-7. [Google Scholar] [PubMed] [CrossRef]
43. Lapuz A, Tsuchikawa S, Inagaki T, Ma T, Migo V. Production of nanocellulose film from abaca fibers. Crystals. 2022;12(5):601. doi:10.3390/cryst12050601. [Google Scholar] [CrossRef]
44. Wigati LP, Wardana AA, Nkede FN, Fanze M, Wardak MH, Reshaka Kavindi MA, et al. Influence of cellulose nanocrystal formulations on the properties of pregelatinized cornstarch and cornmint essential oil films. Sci Rep. 2025;15(1):18997. doi:10.1038/s41598-025-03318-8. [Google Scholar] [PubMed] [CrossRef]
45. Gao Y, Wang X, Li X, Dai H. An antibacterial composite film based on cellulose acetate/TiO2 nanoparticles. New J Chem. 2020;44(48):20751–8. doi:10.1039/D0NJ04374E. [Google Scholar] [CrossRef]
46. Al Matroushi EA, Greish YE, Meetani MA, Al Shamisi BA. Application of cellulose acetate fibrous membranes in the removal of micro- and submicron solid particulates in drinking water media. Desalin Water Treat. 2016;57(36):15676–86. doi:10.1080/19443994.2015.1131199. [Google Scholar] [CrossRef]
47. Doan TKQ, Chiang KY. Characteristics and kinetics study of spherical cellulose nanocrystal extracted from cotton cloth waste by acid hydrolysis. Sustain Environ Res. 2022;32(1):26. doi:10.1186/s42834-022-00136-9. [Google Scholar] [CrossRef]
48. Chen Y, Tan T, Lee H, Abd Hamid S. Easy fabrication of highly thermal-stable cellulose nanocrystals using Cr(NO3)3 catalytic hydrolysis system: a feasibility study from macro- to nano-dimensions. Materials. 2017;10(1):42. doi:10.3390/ma10010042. [Google Scholar] [PubMed] [CrossRef]
49. Pantoja-Castro MA, González-Rodríguez H. Study by infrared spectroscopy and thermogravimetric analysis of tannins and tannic acid. Rev Latinoam Quim. 2012;39(2):107–12. [Google Scholar]
50. Lisperguer J, Saravia Y, Vergara E. Structure and thermal behavior of tannins from Acacia dealbata bark and their reactivity toward formaldehyde. J Chil Chem Soc. 2016;61(4):3188–90. doi:10.4067/S0717-97072016000400007. [Google Scholar] [CrossRef]
51. Tarani E, Tara M, Samiotaki C, Zamboulis A, Chrissafis K, Bikiaris DN. Preparation and characterisation of high-density polyethylene/tannic acid composites. Polymers. 2024;16(23):3398. doi:10.3390/polym16233398. [Google Scholar] [PubMed] [CrossRef]
52. Yuan HB, Tang RC, Yu CB. Microcrystalline cellulose modified by phytic acid and condensed tannins exhibits excellent flame retardant and cationic dye adsorption properties. Ind Crops Prod. 2022;184(3):115035. doi:10.1016/j.indcrop.2022.115035. [Google Scholar] [CrossRef]
53. Liao J, Brosse N, Pizzi A, Hoppe S. Dynamically cross-linked tannin as a reinforcement of polypropylene and UV protection properties. Polymers. 2019;11(1):102. doi:10.3390/polym11010102. [Google Scholar] [PubMed] [CrossRef]
54. Mubarok M, Azadeh E, Obounou Akong F, Dumarçay S, Gérardin P, Gérardin-Charbonnier C. Effect of tannins addition on thermal stability of furfurylated wood. Polymers. 2023;15(9):2044. doi:10.3390/polym15092044. [Google Scholar] [PubMed] [CrossRef]
55. Xu X, Xu Y, Deng S, Chen X, Essawy H, Lee SH, et al. Graft copolymer of tannin and polyvinyl alcohol with acrylic acid for the preparation of hydrophobic biodegradable film. Prog Org Coatings. 2024;186:108090. doi:10.1016/j.porgcoat.2023.108090. [Google Scholar] [CrossRef]
56. Ben Shalom T, Belsey S, Chasnitsky M, Shoseyov O. Cellulose nanocrystals and corn zein oxygen and water vapor barrier biocomposite films. Nanomaterials. 2021;11(1):247. doi:10.3390/nano11010247. [Google Scholar] [PubMed] [CrossRef]
57. Abdollahi M, Alboofetileh M, Rezaei M, Behrooz R. Comparing physico-mechanical and thermal properties of alginate nanocomposite films reinforced with organic and/or inorganic nanofillers. Food Hydrocoll. 2013;32(2):416–24. doi:10.1016/j.foodhyd.2013.02.006. [Google Scholar] [CrossRef]
58. Pires JRA, Souza VGL, Gomes LA, Coelhoso IM, Godinho MH, Fernando AL. Micro and nanocellulose extracted from energy crops as reinforcement agents in chitosan films. Ind Crops Prod. 2022;186:115247. doi:10.1016/j.indcrop.2022.115247. [Google Scholar] [CrossRef]
59. Peña C, De La Caba K, Eceiza A, Ruseckaite R, Mondragon I. Enhancing water repellence and mechanical properties of gelatin films by tannin addition. Bioresour Technol. 2010;101(17):6836–42. doi:10.1016/j.biortech.2010.03.112. [Google Scholar] [PubMed] [CrossRef]
60. Zhou H, Tong H, Lu J, Cheng Y, Qian F, Tao Y, et al. Preparation of bio-based cellulose acetate/chitosan composite film with oxygen and water resistant properties. Carbohydr Polym. 2021;270(4):118381. doi:10.1016/j.carbpol.2021.118381. [Google Scholar] [PubMed] [CrossRef]
61. Kramar A, Rodríguez Ortega I, González-Gaitano G, González-Benito J. Solution casting of cellulose acetate films: influence of surface substrate and humidity on wettability, morphology and optical properties. Cellulose. 2023;30(4):2037–52. doi:10.1007/s10570-022-05026-2. [Google Scholar] [CrossRef]
62. Aguiar De Oliveira LV, Checca Huaman NR, Monteiro SN, Costa UO, Vitorazi L. Characterization and optimization of cerium oxide nanoparticle-doped cellulose acetate films using the Box-Behnken design. J Mater Res Technol. 2025;35(2):2736–54. doi:10.1016/j.jmrt.2025.01.224. [Google Scholar] [CrossRef]
63. Ghamarpoor R, Fallah A, Eghbali T. Design of bifunctional sandwich-like Co@Si/Ox-MXene nanocomposite to increase the supercapacitor properties and removal of pollutants from wastewater. J Alloys Compd. 2024;983(3):173920. doi:10.1016/j.jallcom.2024.173920. [Google Scholar] [CrossRef]
64. Xu Y, Liu B, Zheng L, Zhou Y, Essawy H, Chen X, et al. Facile fabrication of high-performance composite films comprising polyvinyl alcohol as matrix and phenolic tree extracts. Polymers. 2023;15(6):1424. doi:10.3390/polym15061424. [Google Scholar] [PubMed] [CrossRef]
65. Rahman ML, Heim H-P, Samadder R, Jahan MS, Ruhane TA, Gemmeke N, et al. Performance of jute cellulose nanocrystal-reinforced cellulose acetate composite: possible application of spectacle frame. Polym Bull. 2025;82(4):1777–98. doi:10.1007/s00289-024-05593-3. [Google Scholar] [CrossRef]
66. Jin H, Goldberg W, Wang Z, Li H, Huang Y, Foston M, et al. Domain structure and interface control of mechanical stiffness in sustainable cellulose bio-nanocomposites. arXiv:2412.13210. 2024. doi:10.48550/arXIV.2412.13210. [Google Scholar] [CrossRef]
67. Halim ALA, Kamari A, Phillip E. Chitosan, gelatin and methylcellulose films incorporated with tannic acid for food packaging. Int J Biol Macromol. 2018;120(2013):1119–26. doi:10.1016/j.ijbiomac.2018.08.169. [Google Scholar] [PubMed] [CrossRef]
68. Fleck N, Oliveira WCD, Padilha RL, Brandelli A, Sant’Anna V. Antimicrobial effect of phenolic-rich jaboticaba peel aqueous extract on Staphylococcus aureus and Escherichia coli. Braz J Food Technol. 2023;26(4):e2022087. doi:10.1590/1981-6723.08722. [Google Scholar] [CrossRef]
69. Karthega M, Pranesh M, Poongothai C, Srinivasan N. Poly caprolactone/titanium dioxide nanofiber coating on AM50 alloy for biomedical application. J Magnes Alloys. 2021;9(2):532–47. doi:10.1016/j.jma.2020.07.003. [Google Scholar] [CrossRef]
70. Sadeghi A, Razavi SMA, Shahrampour D. Fabrication and characterization of biodegradable active films with modified morphology based on polycaprolactone–polylactic acid–green tea extract. Int J Biol Macromol. 2022;205(1):341–56. doi:10.1016/j.ijbiomac.2022.02.070. [Google Scholar] [PubMed] [CrossRef]
71. Bayat G, Fallah-Darrehchi M, Zahedi P, Moghaddam AB, Ghaffari-Bohlouli P, Jafari H. Kiwi extract-incorporated poly(ε-caprolactone)/cellulose acetate blend nanofibers for healing acceleration of burn wounds. J Biomater Sci Polym Ed. 2023;34(1):72–88. doi:10.1080/09205063.2022.2110483. [Google Scholar] [PubMed] [CrossRef]
72. Erceg T, Vukić N, Šovljanski O, Stupar A, Šergelj V, Aćimović M, et al. Characterization of films based on cellulose acetate/poly(caprolactone diol) intended for active packaging prepared by green chemistry principles. ACS Sustain Chem Eng. 2022;10(28):9141–54. doi:10.1021/acssuschemeng.2c02009. [Google Scholar] [CrossRef]
73. Pino-Otín MR, Lorca G, Val J, Ferrando N, Ballestero D, Langa E. Ecotoxicological study of tannic acid on soil and water non-target indicators and its impact on fluvial and edaphic communities. Plants. 2023;12(23):4041. doi:10.3390/plants12234041. [Google Scholar] [PubMed] [CrossRef]
74. Yang Z-Y, Wang W-J, Shao Z-Q, Zhu H-D, Li Y-H, Wang F-J. The transparency and mechanical properties of cellulose acetate nanocomposites using cellulose nanowhiskers as fillers. Cellulose. 2013;20(1):159–68. doi:10.1007/s10570-012-9796-z. [Google Scholar] [CrossRef]
75. Attari N, Hausler R. Reinforcing effects of fibrous and crystalline nanocelluloses on cellulose acetate membranes. Carbohydr Polym Technol Appl. 2023;5(9):100281. doi:10.1016/j.carpta.2023.100281. [Google Scholar] [CrossRef]
76. Jiang L, Li K, Yang H, Liu X, Li W, Xu W, et al. Improving mechanical properties of electrospun cellulose acetate nanofiber membranes by cellulose nanocrystals with and without polyvinylpyrrolidone. Cellulose. 2020;27(2):955–67. doi:10.1007/s10570-019-02830-1. [Google Scholar] [CrossRef]
77. Denton CD, Focke WW, Ramjee S, Wesley-Smith J. Cellulose acetate reinforced with acetylated nanocellulose fibres. Chem Afr. 2025. doi:10.1007/s42250-025-01389-8. [Google Scholar] [CrossRef]
78. Bouftou A, Aghmih K, Lakhdar F, Abidi N, Gmouh S, Majid S. Enhancing cellulose acetate film with green plasticizers for improved performance, biodegradability, and migration study into a food simulant. Meas Food. 2024;15:100180. doi:10.1016/j.meafoo.2024.100180. [Google Scholar] [CrossRef]
Cite This Article
Copyright © 2026 The Author(s). Published by Tech Science Press.This work is licensed under a Creative Commons Attribution 4.0 International License , which permits unrestricted use, distribution, and reproduction in any medium, provided the original work is properly cited.


Submit a Paper
Propose a Special lssue
View Full Text
Download PDF
Downloads
Citation Tools